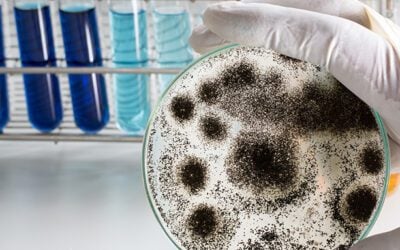
The 5 Best Mold Testing Laborotories In San Diego County, CA

When it comes to mold testing, choosing the right laboratory or service can make all the difference in getting accurate results you can trust. Each of the top five options listed below in San Diego County offers something unique—whether it’s unmatched analytical...
How effective is surface sampling compared to air sampling
Surface sampling and air sampling are both valuable methods for mold detection, each with its own strengths and applications. Professionals decide between air and surface sampling based on several factors, considering the specific situation and goals of the mold...
How much does a mold inspection with testing cost in San Diego, California
In San Diego County, the average cost for a professional mold inspection with testing typically falls between $350 and $600 or more. However, it's important to note that the cost of these services can vary depending on several factors, including the company, size of...
Learn how to get your home tested for mold
If you suspect that you have a mold problem, it is crucial to conduct a thorough mold inspection and testing to identify the extent of the problem and develop an effective remediation plan. Here’s a step-by-step guide on how to get your house tested for mold,...